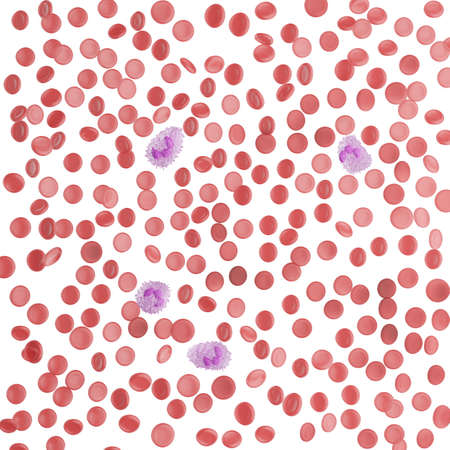
Leukocyte. white blood cells. Protection against viruses and bacteria. The concept of science and medicine. View of neutrophils under the microscope. 3d rendering.の写真素材

写真素材 - Leukocyte. white blood cells. Protection against viruses and bacteria. The concept of science and medicine. View of neutrophils under the microscope. 3d rendering.
作品情報
Leukocyte. white blood cells. Protection against viruses and bacteria. The concept of science and medicine. View of neutrophils under the microscope. 3d rendering.
- ID:182446137
- 作品種別:写真
- 作者名:Григорий Ялуков
キーワード
- 3d render
- abstract
- anatomy
- antigen
- artery
- background
- biology
- blood
- cell
- circulatory
- disease
- erythrocyte
- flow
- health
- healthcare
- healthy
- hemoglobin
- human
- immune
- immunity
- immunology
- infection
- leukocyte
- leukocytes
- lymphocyte
- medical
- medicine
- microbiology
- microscope
- microscopic
- platelet
- red
- research
- science
- scientific
- structure
- vascular
- vein
- vessel
類似作品
Bacteria Franci...
Red blood cells...
texture of a st...
Red blood cells...
red and white b...
Red blood cells...
Healthy human r...
3d rendered med...
A vivid, close-...
Blood cells, do...
White Blood Cel...
Detailed Illust...
A highly detail...
This visual hig...
Microscopic Vie...
Selective focus...
Fresh raspberri...
3d rendering of...
A red blood cel...
red porous surf...
Anatomy and His...
Red blood cells...
Immune System D...
Abstract biolog...
Fresh blueberri...
Microscopic Vie...
Two red and whi...
Polycythemia ve...
Medical Backgro...
3d illustration...
Veillonella bac...
Abstract 3D Ren...
3d rendered med...
Blood cells in ...
Defocused glitt...
Veillonella bac...
Red blood cells...
The blueberries...
a close up of r...
This image show...